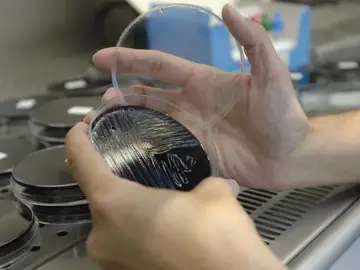
Una muestra es analizada en un laboratorio, en busca del foco de legionela Una muestra es analizada en un laboratorio, en busca del foco de legionela

Más de 100 días con síntomas de coronavirus: "Tengo miedo de quedarme así"

'Corazones de papel', la bonita iniciativa del Grupo Secuoya para enviar mensajes a los enfermos de coronavirus

"Me dijo llorando que no les mandaban ambulancias y habían muerto 4 ancianos con coronavirus"

"Un paseo por la calle puede resultar estar mañana intubado en una UCI"

'Pequeños Guerreros', la iniciativa de los Bomberos de Madrid para ayudar a niños enfermos

Los enfermos ya pueden recibir la visita de sus mascotas en algunos hospitales: "Es un gran alivio"

Un avión, puesto en cuarentena en el aeropuerto de Nueva York tras enfermar diez de sus pasajeros

Las nuevas instalaciones de un campus en China provocan que 65 estudiantes enfermen

Un estudio revela que el consumo de café no influye en el deterioro físico de las personas mayores

Aumentan a 40 los casos de hepatitis A por el brote de un restaurante de Palma
Un brote de legionela en Portugal deja cinco muertos y 50 heridos



